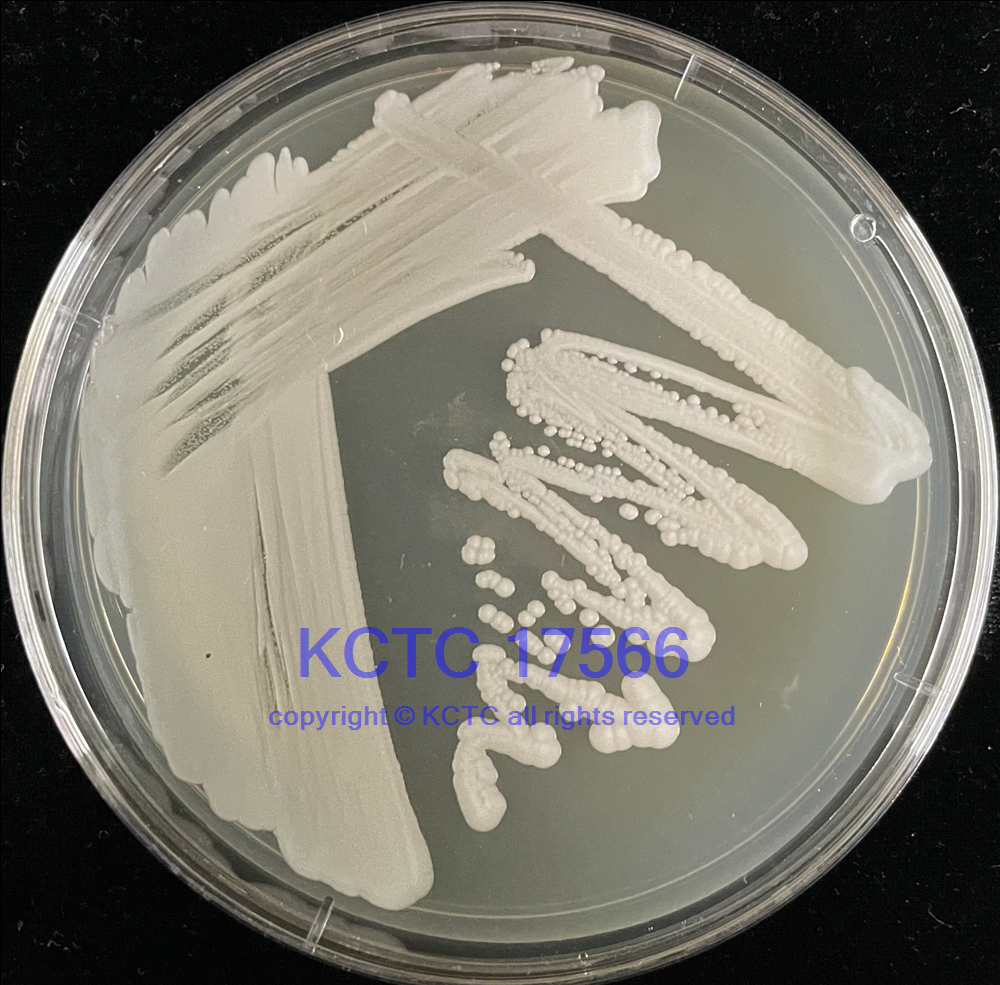

Ogataea polymorpha (Morais et Maia) Yamada, Maeda et Mikata 拉丁名
ATCC 14754 編號
Deposited As Hansenula angusta Wickerham, teleomorph
Strain Designations 菌種別名 NRRL Y-1798 [ATCC 24609, CBS 1976, CCRC 22167, IFO 0799, JCM 3620, NCYC 495, VKM Y-1397, VKPM Y-123] KCTC17566
Biosafety Level 安全等級 1
Biosafety classification is based on U.S. Public Health Service Guidelines, it is the responsibility of the customer to ensure that their facilities comply with biosafety regulations for their own country.
Product Format 提供形式 freeze-dried
Type Strain 模式菌株 yes (type strain of Hansenula angusta)
Preceptrol no
Morphology
After 3 days at 25°C an YM medium cells are spheroidal to elongate, (1.5-4.6) x (1.9-5.3) um, single in pairs, or in small clusters. Growth is butyrous and tannish-white in color.
Medium 培養(yǎng)基 ATCC Medium 200: YM agar or YM broth
Growth Conditions 生長條件
Temperature 培養(yǎng)溫度 : 24.0°C
Sequenced Data
GenBank accession number: FJ914920
18S ribosomal RNA gene, partial sequence; internal transcribed spacer 1, 5.8S ribosomal RNA gene, and internal transcribed spacer 2, complete sequence; and 28S ribosomal RNA gene, partial sequence.
GTTTCCGTAGGTGAACCTGCGGAAGGATCATTACAGTATTCTTCTAAGCTGGAGCTGCTGATCGACTGAACTGTTTGCCTGCGCTGCTGAAATATTGCGTGCGCGGCGATGGTTTTTTTGGTTGCAGTTCTACTCAAGGCTTAGAAATCTCCTTACACACTTTGTTTTCTTATTAGAGACAAATTTGCTTTGGCTAGCGGTCGCTTAAGCGCGGCATGGCTGGCCAGAGGTTTTAACAAAACTCATTTTCGTCTTGCCCATGTGGGGAAGACTGAAAACTTGTATTATGATTTTGTCAGTTATAAGAAGTTGCGTTTGCAGCTTTTCTAAACTTCAAAACTTTCAACAACGGATCTCTTGGTTCTCGCATCGATGAAGAACGCAGCGAAATGCGATACGTAATGTGAATTGCAGATTTTCGTGAATCATTGAATCTTTGAACGCACATTGCGCCCTCTGGTATTCCAGAGGGCATGCCTGTTTGAGCGTCATTTCCCTCTCAAACCCTCGGGTTTGGTGATGGGCAATACTCTCTTTTCTGAGAGTTTGCTTGAAATGAATTGGCATGAGTTTTTGATACGAACTTCAGCTGTTTATTCAATGTATTAGGTTTTATCCATCGTTGATTGACAACTGCAAGCTTCTTTCAAAAATTGGCTCTGCCTTACAAACTTTAATCATAAAGTTTGACCTCAAATCAGGTAGGATTACCCGCTGAACTTAAGCAT
GenBank accession number: FJ914937
Large subunit ribosomal RNA gene, partial sequence.
CATATCAATAAGCGGAGGAAAAGAAACCAACAGGGATTGCCTTAGTAGCGGCGAGTGAAGCGGCAAGAGCTCAAATTTGAAATCTGGTACCTTCGGTGCCCGAGTTGTAATTTGAAGAAAGCTATCTTGGAGGTGGCCCTTGTCTATGTTCCTTGGAACAGGACGTCATGGAGGGTGAGAATCCCGTGTGATGAGGTGTCCATTTCCGTGTAAGATGCTTTCGAAGAGTCGAGTTGTTTGGGAATGCAGCTCAAAGTGGGTGGTAAATTCCATCTAAAGCTAAATATTGGCGAGAGACCGATAGCGAACAAGTACTGTGAAGGAAAGATGAAAAGAACTTTGAAAAGAGAGTGAAAAAGTACGTGAAATTGTTGAAAGGGAAGGGTATTTGATCAGACTTGGTATTTAGCTATCATCGCTCCTTGTGGGTGGTGCTCTAGCTTTTTACTGGGCCAGCATCAGTTTTGGTGGCAAGATAATGACAGTTGAATGTGGCTCCTCGGAGTGTTATAGCTTCTGTTGATGTTGCCTACCGAGACTGAGGTCTGCGGCTTTTGCCTAGGATGCTGGCGTAATGATCCAATACCGC
Morphology
After 3 days at 25°C an YM medium cells are spheroidal to elongate, (1.5-4.6) x (1.9-5.3) um, single in pairs, or in small clusters. Growth is butyrous and tannish-white in color.
Name of Depositor 寄存者 NRRL
Isolation 分離基物
spoiled orange juice, Florida
Cross References
Nucleotide (GenBank) : FJ914937 D1/D2 region of 28S rRNA gene
Nucleotide (GenBank) : FJ914920 ITS including 5.8S rRNA gene
References 參考文獻(xiàn)
Wickerham LJ. Taxonomy of yeasts. U.S. Dep. Agric. Tech. Bull. 1029: 1951..
Titorenko VI, et al. Identification and characterization of cytosolic Hansenula polymorpha proteins belonging to the Hsp70 protein family. Yeast 12: 849-857, 1996. PubMed: 8840502
Baerends RJ, et al. Deviant Pex3p levels affect normal peroxisome formation in Hansenula polymorpha: high steady-state levels of the protein fully abolish matrix protein import. Yeast 13: 1437-1448, 1997. PubMed: 9434349
Suh SO, Zhou JJ. Methylotrophic yeasts near Ogataea (Hansenula) polymorpha: a proposal of Ogataea angusta comb. nov. and Candida parapolymorpha sp.nov. FEMS Yeast Res. 10: 631-638, 2010. PubMed: 20491937
type strain of Hansenula angusta
type strain of Hansenula angusta
ATCC14754